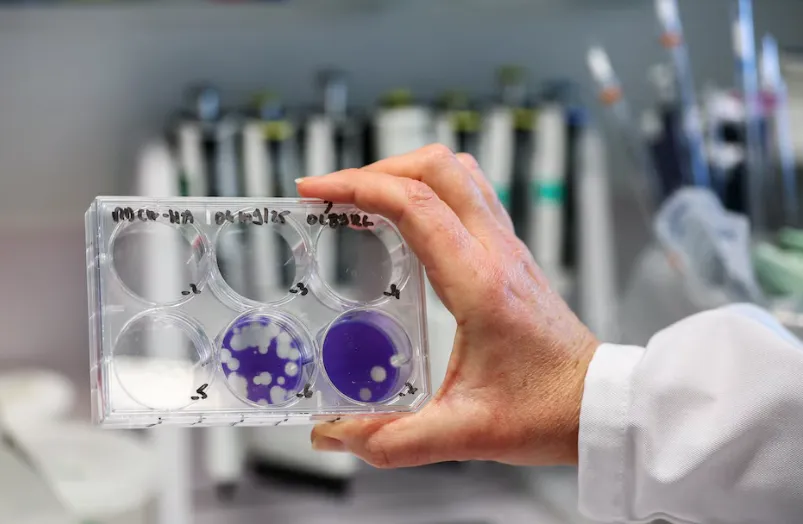
multimedia.normal.aa5764936df1461b.bm9ybWFsLndlYnA=

Salud refuerza las medidas de prevención ante la circulación de la variante de influenza K
Prensa
El Ministerio de Salud Pública informa sobre la situación epidemiológica actual respecto a la Influenza A (H3N2), con especial énfasis en la identificación del subclado K (también denominado J.2.4.1), una variante de reciente expansión en el país.
Medidas de prevención y cuidado diario
La influenza es un virus respiratorio de fácil transmisión que se propaga a través de gotitas al hablar, toser o estornudar, y mediante el contacto con superficies contaminadas. Para reducir el riesgo de contagio, se solicita reforzar las siguientes acciones:
Higiene de manos: Lavado frecuente con agua y jabón o uso de alcohol en gel.
Ventilación: Mantener los ambientes ventilados, incluso en días frescos.
Etiqueta respiratoria: Cubrirse la boca y nariz con el pliegue del codo al toser o estornudar.
Responsabilidad individual: No compartir mate, vasos o cubiertos. En caso de presentar síntomas, se recomienda el uso de barbijo y el aislamiento domiciliario hasta la recuperación para proteger a los grupos más vulnerables.
Importancia de la Vacunación Antigripal 2026
La vacunación es la herramienta más efectiva para prevenir complicaciones graves, internaciones y fallecimientos. La campaña de inmunización prioriza a:
Personal de salud y embarazadas en cualquier trimestre.
Niños de 6 a 24 meses y adultos mayores de 65 años.
Personas con factores de riesgo (diabetes, enfermedades cardíacas, respiratorias crónicas, obesidad o inmunocomprometidos).
Situación Epidemiológica: Influenza A "Gripe K" en Salta
De acuerdo con el último reporte del Programa de Vigilancia por Redes de Laboratorio de Salta, hasta la Semana Epidemiológica (SE) 8 se han estudiado un total de 15 muestras mediante vigilancia genómica. Los resultados confirman la circulación en el territorio provincial de variantes específicas: se identificaron 3 casos correspondientes al subclado J.2.4.1 (K) y 1 caso perteneciente al subclado J.2.3 de Influenza A (H3N2).
A partir de la investigación realizada por el Programa de Vigilancia Epidemiológica, se ha podido establecer el perfil de los pacientes afectados por esta variante K. En la zona norte, se detectó el caso de un joven de 18 años residente de San Ramón de la Nueva Orán, trabajador de frontera, quien presentó fiebre y dificultad respiratoria requiriendo internación. Asimismo, en Tartagal, se registró un paciente de 36 años con antecedente de viaje reciente a Bolivia y esquema de vacunación contra COVID-19 incompleto, quien cursó un cuadro de rinitis y dolor muscular de manejo ambulatorio.
Por último, se reportó un caso en Apolinario Saravia, correspondiente a un adulto de 72 años con antecedentes de tabaquismo.
Signos de alarma
Se solicita a la población no automedicarse con antibióticos (ya que la influenza es un virus) y realizar una consulta médica urgente ante la presencia de dificultad para respirar, dolor opresivo en el pecho, confusión o fiebre persistente en personas de riesgo.
Fuente: Secretaria de Prensa y Comunicación












